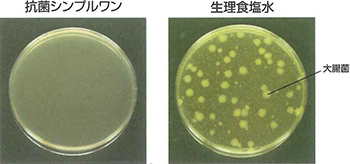
優れた抗菌力

シンプルワン

シンプルワンの4つの特徴
1. 洗浄・保存・タンパク質除去がこれ1本でOK。
シンプルワンは、洗浄・保存・タンパク除去が行える洗浄保存液。
簡単で、効果的なレンズケアを実現します。
さらに抗菌力がプラスされ、レンズケースも清潔に保てます。
- 優れた洗浄力
-
- 抗菌シンプルワンの優れた洗浄力により、タンパク質も洗い落とします。
- 「抗菌シンプルワン」洗浄力試験結果

「抗菌シンプルワン」と他社製品の洗浄効果比較
2. 酵素の力をキープ。簡単&強力な洗浄効果。
リビジュア®(MPCポリマー、生体適合物質)が酵素の力をしっかりキープ。優れた洗浄力を発揮します。
しかも汚れの付着も防止。長期間にわたってクリアな視界を保ちます。
- 優れた抗菌力
-
- 大腸菌を抗菌シンプルワン又は生理食塩水に約10万個/mLになるように接種し、35℃で24時間接触した。各液を生理食塩水で100倍に希釈した後、SCDLP観点培地を用いて35℃、48時間培養した。
「抗菌シンプルワン」と他社製品の抗菌効果実験
3. 各社のハードコンタクトレンズに使用可能。
シンプルワンは、市販されている多くのハードコンタクトレンズに使用できます。
4. リビジュア®でレンズにうるおい。くもりを防止。
保湿性に優れたリピジュア®は、レンズのコンディションも整えてくれる新素材。
レンズにしっとりとうるおいを与えると共に、レンズのくもりを防止します。
- リビジュア®とは
- 医療機器や化粧品に使用されている高分子新素材で、レンズにうるおいを与え、くもりや汚れの付着を防止します。
- 優れた保湿効果
-
- 抗菌シンプルワンでつけおきすることで、リピジュア®(MPCポリマー)のうるおい効果により、レンズの水漏れ性が高まります。
- 「抗菌シンプルワン」と未処理品の水濡れ試験結果

使用方法
はめるとき
石けんで手を洗って清潔に
レンズをホルダーにセットしたまま水道水でよくすすぐ
レンズをはめる
はずすとき
石けんで手を洗って清潔にしてからレンズをはずす
レンズにシンプルワンを数滴たらし、爪が当たらないようにこすり洗いする
レンズは水で充分にすすいでから、シンプルワンを満たしたレンズケースに収納し、保存する
適合レンズ
全てのハードコンタクトレンズに使用できます。
注意事項
- ①本剤の点眼は禁止
- ②ソフトコンタクトレンズへの使用禁止
- ③レンズケース内の本剤は、毎日交換する